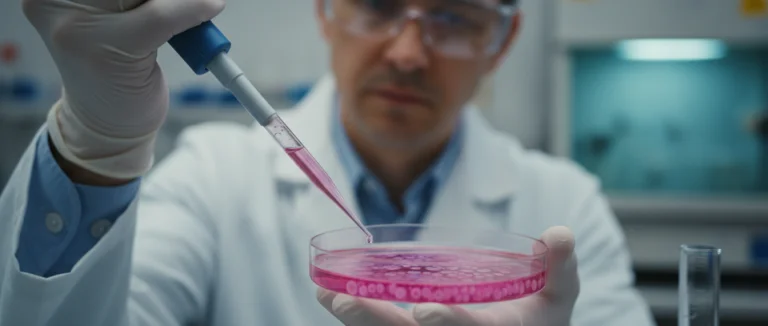
Генетическое редактирование в лаборатории

Индуцированные плюрипотентные клетки: перспективы лечения
-
Что такое индуцированные плюрипотентные стволовые клетки?
-
Как создаются iPSC: процесс пере программирования
-
Клиническое применение iPSC в терапии
-
Роль факторов Яманаки в получении плюрипотентных клеток
-
Перспективы и вызовы: этика
-
безопасность и будущее
-
Почему выбирают Лив Хоспитал
В последние годы индуцированные плюрипотентные стволовые клетки (iPSC) стали одним из самых обсуждаемых достижений биомедицины. Эти клетки способны дифференцироваться во все типы тканей организма, открывая новые возможности для регенеративной терапии. По оценкам экспертов, к 2030 году рынок терапии стволовыми клетками может превысить 30 миллиардов долларов, а iPSC находятся в его ядре.
Статья расскажет о том, что представляют собой эти клетки, как их получают, где уже применяют в клинической практике и какие вызовы стоят перед учёными. Мы также рассмотрим роль факторов Яманаки в процессе пере программирования и объясним, почему Лив Хоспитал предлагает инновационные программы лечения на их основе.
Если вы интересуетесь передовыми методами лечения, которые уже доступны в ведущих клиниках Стамбула, продолжайте чтение – вы узнаете, как iPSC могут изменить подход к лечению хронических заболеваний и травм.
Что такое индуцированные плюрипотентные стволовые клетки?

Термин индуцированные плюрипотентные стволовые клетки обозначает клетки, полученные из взрослых соматических клеток (например, кожи) путём введения специальных генов. После пере программирования такие клетки возвращаются в состояние, сходное с эмбриональными стволовыми клетками, но без этических проблем, связанных с использованием эмбрионов.
Ключевые свойства iPSC:
- Плюрипотентность – способность дифференцировать в любой тип клеток организма.
- Самообновляемость – возможность многократного деления без потери потенциала.
- Индивидуальность – клетки могут быть получены из ткани конкретного пациента, что снижает риск иммунного отторжения.
Эти свойства делают их идеальными кандидатами для создания персонализированных терапий, а также для моделирования заболеваний в лабораторных условиях.
Как создаются iPSC: процесс пере программирования
Создание индуцированных плюрипотентных стволовых клеток начинается с выбора исходного материала – обычно берут кожные фибробласты пациента. Затем в клетки вводятся четыре гена, известные как факторы Яманаки (OCT4, SOX2, KLF4 и c-MYC), которые активируют программы развития, характерные для эмбриональных клеток.
Существует несколько методов доставки генов:
| Метод | Преимущества | Недостатки |
|---|---|---|
| Вирусные векторы (Retrovirus, Lentivirus) | Высокая эффективность трансдукции | Риск интеграции в геном |
| Невирусные плазмиды | Безопаснее, не интегрируются | Низкая эффективность |
| mRNA‑трансфер | Отсутствие геномных изменений | Требует повторных дозировок |
| Электропорация | Контролируемый ввод ДНК | Может повредить клетки |
После введения факторов клетки проходят несколько дней культивирования, в течение которых они меняют морфологию и начинают экспрессировать маркеры плюрипотентности, такие как NANOG и TRA‑1‑60. На этом этапе исследователи проверяют качество полученных iPSC, используя методы иммунофлюоресцентного анализа и генетического секвенирования.
Клиническое применение iPSC в терапии

На сегодняшний день индуцированные плюрипотентные стволовые клетки уже применяются в нескольких клинических испытаниях, охватывающих широкий спектр заболеваний:
- Кардиология: создание кардиомиоцитов для восстановления повреждённого сердца после инфаркта.
- Неврология: дифференцировка в нейроны и глиальные клетки для лечения Паркинсона и спинальной мышечной атрофии.
- Гематология: генерация гемопоэтических стволовых клеток для лечения анемий и лейкемий.
- Офтальмология: выращивание ретинальных клеток для восстановления зрения при возрастной макулярной дегенерации.
Ключевым преимуществом iPSC‑терапии является возможность создания автологичных клеток, что минимизирует риск отторжения и необходимости длительной иммуносупрессии. В Лив Хоспитал уже реализованы программы по подготовке iPSC‑препаратов для персонализированных онкологических и неврологических протоколов.
Роль факторов Яманаки в получении плюрипотентных клеток
Открытие факторов Яманаки в 2006 году стало прорывом, позволившим преобразовать обычные соматические клетки в плюрипотентные. Каждый из факторов играет свою роль в активации генов, отвечающих за поддержание недифференцированного состояния.
Краткая характеристика факторов:
| Фактор | Функция | Особенности |
|---|---|---|
| OCT4 | Поддерживает плюрипотентность | Ключевой регулятор ранних эмбриональных генов |
| SOX2 | Синергизирует с OCT4 | Участвует в формировании нейрональных линий |
| KLF4 | Регулирует клеточный цикл | Помогает избежать апоптоза при пере программировании |
| c-MYC | Ускоряет рост клеток | Онкогенный, поэтому часто заменяется на менее опасные аналоги |
Современные лаборатории, включая Лив Хоспитал, используют модифицированные версии факторов (например, без c-MYC) для повышения безопасности получаемых iPSC. Кроме того, исследователи разрабатывают небольшие молекулы, способные имитировать действие факторов, что может полностью исключить генетическую модификацию.
Перспективы и вызовы: этика, безопасность и будущее
Несмотря на впечатляющие результаты, индуцированные плюрипотентные стволовые клетки сталкиваются с рядом вызовов. Среди главных вопросов – этика получения и использования генетически модифицированных клеток, а также потенциальный риск образования опухолей.
Ключевые вызовы:
- Этические аспекты: хотя iPSC не требуют эмбрионов, вопросы о генетической модификации остаются актуальными.
- Онкогенность: некоторые факторы (например, c-MYC) могут способствовать трансформации клеток.
- Стандартизация производства: необходимы строгие протоколы GMP для клинического применения.
- Регуляторные барьеры: разные страны имеют различную законодательную базу для одобрения iPSC‑терапий.
Будущее, по мнению экспертов, связано с развитием «безгенетических» методов пере программирования, улучшением методов контроля качества и расширением клинических испытаний. Лив Хоспитал уже участвует в международных проектах, направленных на создание безопасных iPSC‑препаратов для лечения редких генетических болезней.
Почему выбирают Лив Хоспитал
Лив Хоспитал – аккредитованная JCI сеть частных больниц в Стамбуле, специализирующаяся на передовых методах терапии, включая стволовые клетки. Мы предоставляем полное сопровождение иностранных пациентов: от записи на приём и трансфера до услуг переводчика и организации проживания. Наши специалисты имеют многолетний опыт работы с iPSC и предлагают индивидуальные программы лечения, основанные на последних научных достижениях.
Готовы узнать, как индуцированные плюрипотентные стволовые клетки могут изменить ваш план лечения? Свяжитесь с нашими экспертами уже сегодня, и мы подберём оптимальную программу, учитывая ваши индивидуальные потребности.
Часто задаваемые вопросы
Индуцированные плюрипотентные стволовые клетки (iPSC) получают из взрослых тканей, например, кожи, с помощью пере программирования генов. В процесс вводятся четыре ключевых фактора Яманаки – OCT4, SOX2, KLF4 и c‑MYC, которые активируют программы развития, характерные для эмбриональных стволовых клеток. После этого клетки приобретают плюрипотентность, то есть способны дифференцировать в любой тип клеток организма, при этом сохраняют генетический материал пациента, что снижает риск иммунного отторжения. iPSC открывают возможности для персонализированных терапий и моделирования заболеваний в лаборатории.
Процесс начинается с получения исходного материала – обычно кожных фибробластов. Затем в клетки вводятся четыре гена‑фактора (OCT4, SOX2, KLF4, c‑MYC) различными методами: вирусные векторы (Retrovirus, Lentivirus) обеспечивают высокую эффективность, но несут риск интеграции; невирусные плазмиды безопаснее, но менее эффективны; mRNA‑трансфер исключает геномные изменения, требуя повторных доз; электропорация позволяет контролировать ввод ДНК, но может повредить клетки. После нескольких дней культивирования клетки меняют морфологию и начинают экспрессировать маркеры плюрипотентности, такие как NANOG и TRA‑1‑60, после чего их качество проверяется иммунофлюоресцентным анализом и секвенированием.
Вирусные векторы (Retrovirus, Lentivirus) обладают высокой трансдукционной эффективностью, однако могут интегрироваться в геном, что повышает риск онкогенности. Невирусные плазмиды не интегрируются, но их эффективность ниже. mRNA‑трансфер вводит синтетический мРНК, что полностью исключает геномные изменения, однако требует многократных дозировок для поддержания экспрессии факторов. Электропорация использует короткие электрические импульсы для создания пор в мембране клетки, позволяя вводить ДНК или мРНК, но может вызвать клеточный стресс и повреждения. Выбор метода зависит от требуемой эффективности, безопасности и целей исследования.
В кардиологии iPSC дифференцируют в кардиомиоциты для восстановления после инфаркта. В неврологии получаются нейроны и глиальные клетки, применяемые при лечении болезни Паркинсона и спинальной мышечной атрофии. В гематологии генерируют гемопоэтические стволовые клетки для терапии анемий и лейкемий. В офтальмологии выращивают ретинальные клетки, способные восстанавливать зрение при возрастной макулярной дегенерации. Все эти подходы основаны на автологичности iPSC, что минимизирует риск отторжения и необходимость длительной иммуносупрессии.
Онкогенность возникает из‑за использования онкогенных факторов, таких как c‑MYC, которые могут способствовать трансформации клеток в опухолевые. Этические вопросы связаны с генетической модификацией и потенциальным применением в репродуктивных целях. Кроме того, отсутствие единых международных стандартов GMP для производства iPSC усложняет их клиническое внедрение. Регуляторные барьеры в разных странах также могут задерживать одобрение новых терапий. Современные исследования стремятся к «безгенетическим» методам пере программирования и улучшенному контролю качества, чтобы снизить эти риски.
Лив Хоспитал, как аккредитованная сеть JCI, разрабатывает индивидуальные протоколы лечения на основе iPSC, полученных из тканей конкретного пациента. Программы включают создание автологичных кардиомиоцитов, нейронов и гемопоэтических клеток, которые затем вводятся в организм для восстановления повреждённых тканей. Больница использует модифицированные версии факторов Яманаки без c‑MYC и исследует небольшие молекулы, имитирующие их действие, что повышает безопасность продукции. Кроме того, Лив Хоспитал участвует в международных проектах по стандартизации GMP‑процессов и проведению клинических испытаний новых iPSC‑терапий.
* Содержимое нашего сайта предназначено только для информационных целей. Обязательно обратитесь к врачу для диагностики и лечения. В содержание страницы не включены элементы, содержащие информацию о терапевтических медицинских услугах в Лив Госпитале.












